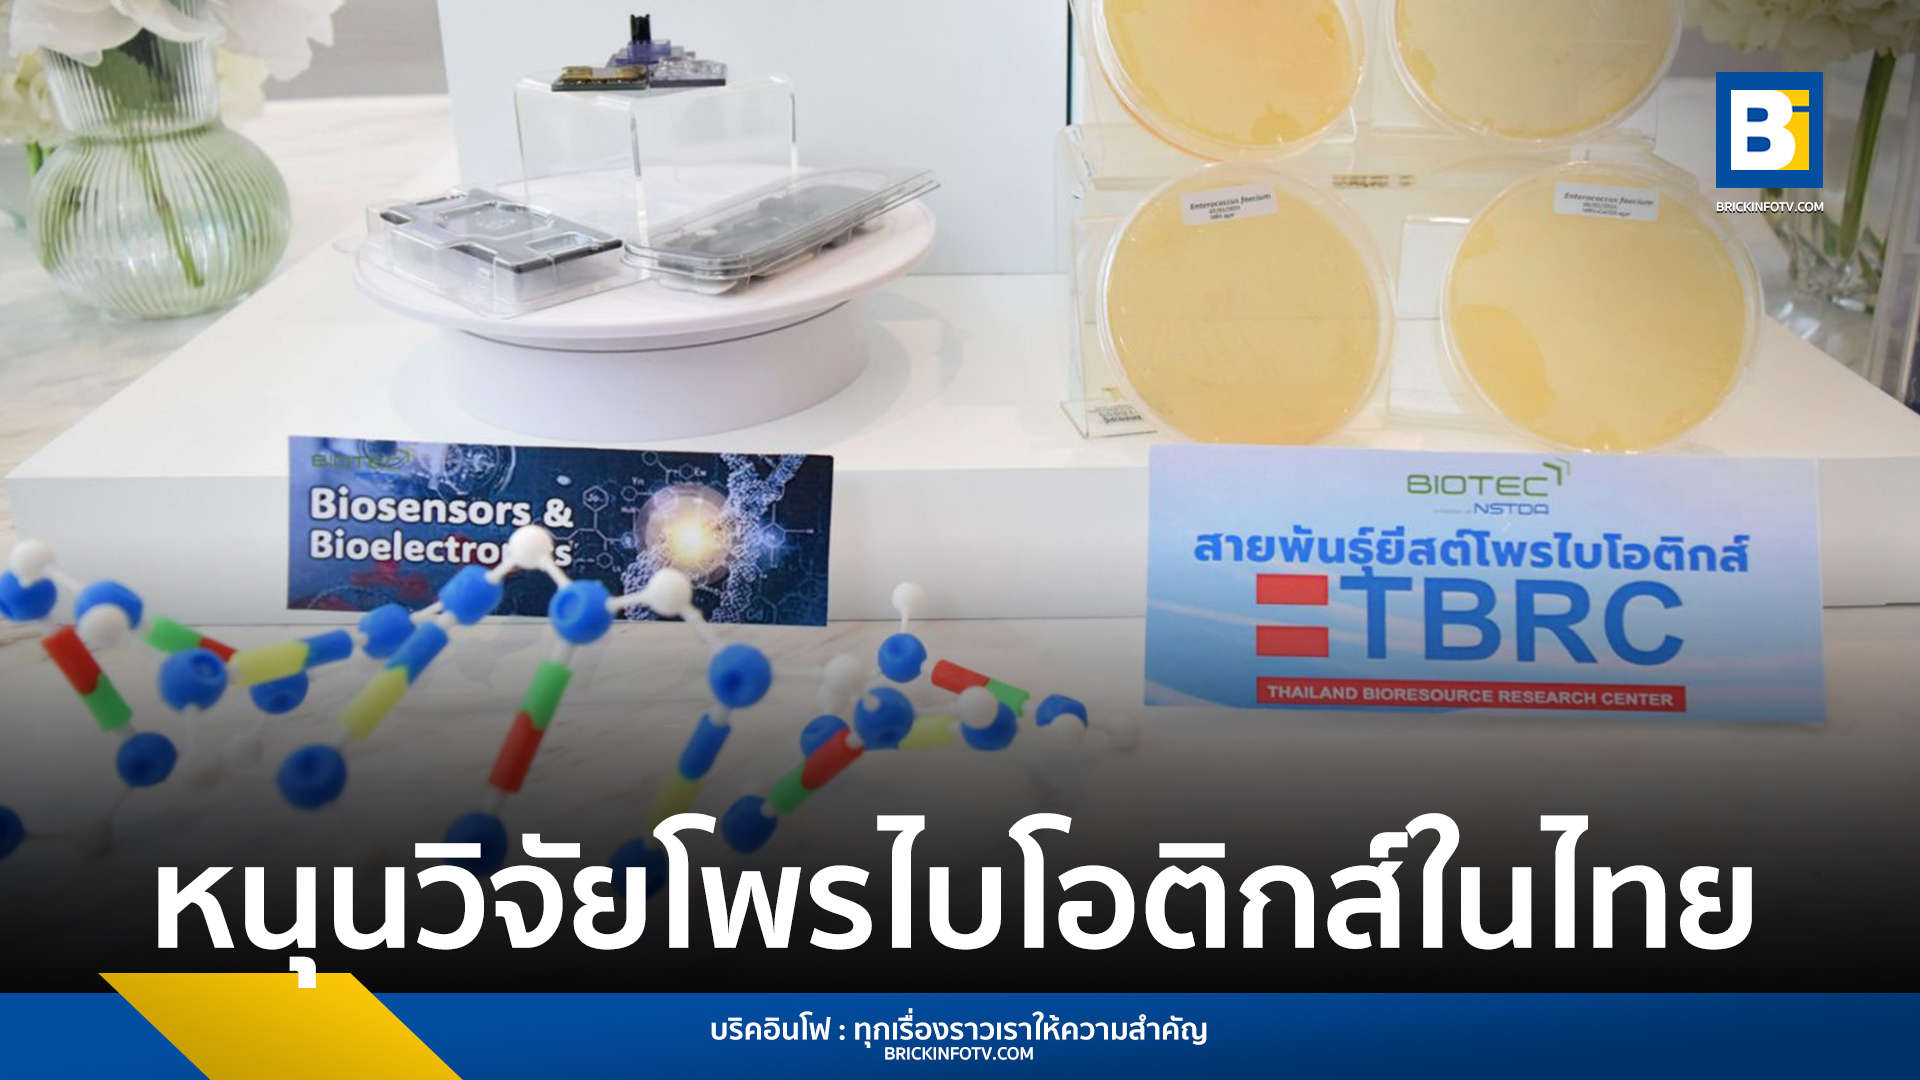

ข่าว
BIOTEC จับมือ BioMed และสมาคมจุลินทรีย์ลำไส้ฮ่องกง ร่วมวิจัยเสริมอุตสาหกรรมด้านจุลินทรีย์และโพรไบโอติกส์ในไทย
ศูนย์พันธุวิศวกรรมและเทคโนโลยีชีวภาพแห่งชาติ (ไบโอเทค) สำนักงานพัฒนาวิทยาศาสตร์และเทคโนโลยีแห่งชาติ (สวทช.) ร่วมกับ บริษัท ไบโอเมด เทคโนโลยี โฮลดิ้งส์ ประเทศไทย จำกัด (BioMed) และสมาคมจุลินทรีย์ลำไส้ฮ่องกง (HKSGM) ลงนามข้อตกลงความร่วมมือทางการวิจัยและวิชาการในวันที่ 10 พฤษภาคม 2567 ที่โรงแรม Park Hyatt กรุงเทพฯ โดยมีจุดประสงค์ในการศึกษาวิจัย แลกเปลี่ยนองค์ความรู้ พัฒนานวัตกรรม เพื่อส่งเสริมอุตสาหกรรมด้านจุลินทรีย์และโพรไบโอติกส์ในประเทศไทย
ร่างกายมนุษย์ประกอบด้วยเซลล์จำนวนมากกว่า 100 ล้านล้านเซลล์ แต่เซลล์มนุษย์แท้จริงมีเพียง 30 ล้านเซลล์ ที่เหลืออีกกว่า 100 ล้านล้านเซลล์ เป็นเซลล์ของจุลินทรีย์ ซึ่งอาศัยอยู่ในส่วนต่าง ๆ ของร่างกาย เมื่อจุลินทรีย์เหล่านี้อาศัยอยู่รวมกันเป็นระบบนิเวศขนาดใหญ่จะเรียกว่า “ไมโครไบโอม” (Microbiome) ซึ่งหมายถึงสังคมจุลินทรีย์ เช่น ไมโครไบโอมในลำไส้จะประกอบไปด้วยจุลินทรีย์ชนิดต่าง ๆ มีความหลากหลายในแต่ละบุคคล จุลินทรีย์ที่พบในระบบทางเดินอาหารเหล่านี้มีทั้งชนิดดีที่ช่วยทำหน้าที่ย่อยอาหาร เสริมการเผาผลาญ ดูแลระบบภูมิคุ้มกัน สังเคราะห์วิตามิน และช่วยปรับสมดุลให้ร่างกาย สมอง และอารมณ์ และกลุ่มจุลินทรีย์ที่ก่อโรค เมื่อองค์ประกอบของไมโครไบโอมมีความสมดุลจะส่งผลให้การทำงานของร่างกายเป็นปกติ แต่หากเกิดการเปลี่ยนแปลงขององค์ประกอบของไมโครไบโอมทำให้เกิดการเสียสมดุล (dysbiosis) จะสามารถก่อให้เกิดโรค หรือความผิดปกติได้

ดร.วรรณพ วิเศษสงวน ผู้อำนวยการศูนย์พันธุวิศวกรรมและเทคโนโลยีชีวภาพแห่งชาติ สวทช. เปิดเผยว่า ทีมวิจัยจากไบโอเทค มีการศึกษาเรื่องไมโครไบโอมในเชิงลึก ด้วยการพัฒนาเทคโนโลยีฐาน multi-omics ที่ครอบคลุมทั้งองค์ความรู้ไมโครไบโอม (microbiome) การตอบสนองของสิ่งมีชีวิตที่ระดับยีน (transcriptome) และเมตาบอไลท์ (metabolome) เพื่อนำมาศึกษาความสำคัญและปฏิสัมพันธ์ระหว่างกลุ่มประชากรแบคทีเรียในลำไส้ต่อระบบภูมิคุ้มกันของสิ่งมีชีวิต องค์ความรู้และเทคโนโลยีฐานที่ได้พัฒนาขึ้นช่วยให้การศึกษาไมโครไบโอม มีความแม่นยำและละเอียดลึกมากขึ้น ช่วยให้การวิจัยและพัฒนาด้านไมโครไบโอม สามารถนํามาสู่การใช้ประโยชน์ได้อย่างมีประสิทธิภาพและยั่งยืน ความเข้าใจการอยู่รวมกันของกลุ่มจุลินทรีย์กับเซลล์เจ้าภาพ หรือสิ่งแวดล้อม ช่วยให้เราสามารถออกแบบสภาพแวดล้อมเพื่อปรับเปลี่ยนและควบคุมให้จุลินทรีย์มีคุณสมบัติหรือเป็นแหล่งผลิตสารชีวภาพที่อุตสาหกรรมหลากหลายประเภทที่เราต้องการได้ ในปัจจุบันการวิจัยไมโครไบโอมในมนุษย์มีความก้าวหน้าอย่างรวดเร็ว มีงานวิจัยที่แสดงให้เห็นถึงผลของอาหารที่มีบทบาทต่อการเปลี่ยนแปลงไมโครไบโอมในลําไส้ ส่งผลต่อการเปลี่ยนแปลงการทำงานของร่างกาย สุขภาพและการเป็นโรคของมนุษย์ แทบจะกล่าวได้ว่าไมโครไบโอมเกี่ยวข้องกับการทำงานในร่างกายทุกส่วนของมนุษย์ ซึ่งนํามาสู่การวิจัยและพัฒนาจุลินทรีย์เสริมสุขภาพหรือโพรไบโอติกส์ (probiotics)
นอกจากนี้ เมื่อปี พ.ศ. 2561 ยังมีงานวิจัยที่ตีพิมพ์ในวารสารทางวิชาการระดับนานาชาติชื่อ Cell Journal เผยแพร่เรื่องการมีไมโครไบโอมในลำไส้ ที่แตกต่างกันของประชากรแต่ละภูมิภาคเนื่องจากอาหารที่บริโภคเข้าไปในร่างกาย
ไบโอเทค BioMed และ HKSGM ได้จับมือร่วมวิจัย พัฒนานวัตกรรมโพรไบโอติกส์ที่เหมาะกับประชากรไทย โดยมุ่งศึกษารูปแบบไมโครไบโอมของประชากรไทยโดยพิจารณาจากปัจจัยด้านภูมิศาสตร์ที่หลากหลายและพฤติกรรมการบริโภคอาหารแต่ละพื้นที่ โดยข้อมูลการศึกษาเชิงลึกที่ได้จากการวิเคราะห์ไมโครไบโอมจะนำมาใช้พัฒนาสูตรผลิตโพรไบโอติกส์และผลิตภัณฑ์เสริมอาหารอื่น ๆ ซึ่งออกแบบมาเพื่อคนไทยโดยเฉพาะ ทั้งนี้ ทั้ง 3 ฝ่ายยังจะมีการศึกษาสายพันธุ์จุลินทรีย์เพื่อผลิตผลิตภัณฑ์โพรไบโอติกส์ที่ปรับให้เหมาะกับความต้องการที่แตกต่างกันของประชากรไทย
ดร.วรรณพ กล่าวต่อว่า BioMed มีความเชี่ยวชาญที่ครอบคลุมตั้งแต่การคัดเลือกสายพันธุ์จุลินทรีย์ การทดสอบคุณสมบัติของโพรไบโอติกส์ การพัฒนากระบวนการผลิตเซลล์จุลินทรีย์โพรไบโอติกส์ในระดับห้องปฏิบัติการ และขยายขนาดการผลิตผลิตภัณฑ์โพรไบโอติกส์ในระดับอุตสาหกรรมที่ครอบคลุมทั้งกระบวนการต้นน้ำ (USP) และกระบวนการปลายน้ำ (DSP) ได้แก่ การผลิตเซลล์ด้วยการหมักแบบเหลว (submerged fermentation) การเก็บเกี่ยวเซลล์ (cell harvesting) การทำแห้ง (cell drying) และการพัฒนาสูตรผลิตภัณฑ์ (product formulation) เพื่อให้ได้ผลิตภัณฑ์โพรไบโอติกส์ที่มีคุณลักษณะตามสเปคที่กำหนดภายใต้มาตรฐาน GMP (Good Manufacturing Practice; GMP) สำหรับใช้เป็นสารเสริมอาหารในมนุษย์ ซึ่งเป็นประโยชน์ต่อความร่วมมือในครั้งนี้
BioMed ในประเทศไทยนั้น มี นพ.พิชัย นำศิริกุล และ นายวันวนัส มาอินทร์ ดำรงตำแหน่ง Chairperson และ CEO ตามลำดับ มีบริษัทแม่อยู่ที่เขตปกครองพิเศษฮ่องกง ซึ่งเก็บสะสมฐานข้อมูลจุลินทรีย์มากว่า 20 ปี ทั้งของคนในประเทศไทย และประเทศอื่น ๆ ทั่วโลก มีศูนย์ปฏิบัติการอยู่ที่ Hong Kong Science and Technology Park (HKSTP) และมีผู้ถือหุ้นที่น่าสนใจอย่าง Alibaba, Chinese University of Hong Kong และ Gobi Partners ซึ่งเรามีวิสัยทัศน์ในการขับเคลื่อนบริษัท บน 3 แนวทาง ได้แก่ 1) เพิ่มจำนวน sample size ของตัวอย่างจุลินทรีย์ 2) ทำงานวิจัย ที่ครอบคลุมกลุ่มโรคมากขึ้น 3) explore แนวทางการรวมโพรไบโอติกส์กับ ingredients อื่นๆ เช่น เห็ด สมุนไพร ฯลฯ โดยปัจจุบันในประเทศไทย บริษัทฯ ได้ให้บริการการตรวจจุลินทรีย์ในลำไส้ ทำให้ทราบว่าโพรไบโอติกส์สายพันธุ์ใดที่พร่องไปในร่างกายของผู้รับการตรวจ ซึ่งจำหน่ายคู่กับโพรไบโอติกส์ทั้งแบบเฉพาะบุคคล (Personalized Probiotics) และยังมีโพรไบโอติกส์แบบทั่วไป (เลือกทานได้โดยไม่ต้องตรวจจุลินทรีย์ก่อน) โดยเลือกสายพันธุ์โพรไบโอติกส์แตกต่างกันตามกลุ่มอาการที่ต้องการการดูแล ซึ่งคิดค้นสูตรจากฐานข้อมูลจุลินทรีย์ของคนในประเทศไทยโดยเฉพาะ

นายวันวนัส มาอินทร์ CEO บริษัท ไบโอเมด เทคโนโลยี โฮลดิ้งส์ ประเทศไทย จำกัด (BioMed) กล่าวเสริมว่า นโยบายของกลุ่มบริษัท BioMed เน้นการพัฒนาผลิตภัณฑ์และการให้บริการ บนแนวคิด scientific และ precision-based กล่าวคือ solution ทุกอย่างที่บริษัทฯ นำเสนอ ต้องมีที่มาที่ไปรองรับอย่างชัดเจนและพิสูจน์ได้ ด้วยเหตุนี้ BioMed ฮ่องกง จึงได้ทุ่มเทงบประมาณ และบุคลากรไปกับการทำวิจัยเกี่ยวกับลักษณะจุลินทรีย์ที่เชื่อมโยงกับกลุ่มโรคผื่นแพ้ผิวหนัง สะเก็ดเงิน โรคทางสมอง ฯลฯ รวมถึงการบรรเทาอาการของโรคดังกล่าว ด้วยการให้กลุ่มตัวอย่างรับประทานโพรไบโอติกส์สายพันธุ์ต่าง ๆ ที่มีงานวิจัยรองรับว่าช่วยบรรเทาโรคดังกล่าวได้ และดูลักษณะการเปลี่ยนแปลงของจุลินทรีย์ ควบคู่ไปกับการสังเกตอาการ ซึ่งงานวิจัยทั้งหมดได้รับการตีพิมพ์ลงวารสารการแพทย์แล้ว โดยความร่วมมือด้านวิชาการและการวิจัย ระหว่าง ไบโอเทค Biomed รวมถึง HKSGM ในประเทศไทยนั้น จะใช้ methodology หรือวิธีการที่ใกล้เคียงกับการวิจัยที่ทำสำเร็จแล้วในฮ่องกง แต่ปรับเปลี่ยนในบางส่วนเพื่อความเหมาะสมสำหรับการวิจัยในไทย ซึ่งต้องอาศัยความรู้ ความเชี่ยวชาญจากไบโอเทคมาประกอบกัน ทำให้ร่นระยะเวลาการทำวิจัยรวมถึงทรัพยากร แต่ยังคงไว้ซึ่งแนวทางนำไปสู่ข้อสรุปด้านจุลินทรีย์ที่เหมาะสมกับคนในประเทศไทย นอกจากนี้ ทั้งสามฝ่ายจะร่วมกันเผยแพร่ความรู้ความเข้าใจเกี่ยวกับจุลินทรีย์และโพรไบโอติกส์ให้กับผู้บริโภคในประเทศไทย ซึ่งเป็นส่วนหนึ่งที่จะช่วยส่งเสริมการขยายตัวของธุรกิจโพรไบโอติกส์ให้เป็นไปอย่างมีคุณภาพ และช่วยให้ผู้บริโภคตระหนักรู้ว่าแท้จริงแล้วโพรไบโอติกส์นั้นมีประโยชน์มากมายกว่าเพียงแค่เรื่องการขับถ่าย
ดร.วรรณพ กล่าวปิดท้ายความร่วมมือครั้งนี้ว่า เราโชคดีและถือเป็นเกียรติมากที่ได้ทำงานร่วมกับ Prof. Stephen Tsui (TSUI Kwok Wing) นอกจากจะเป็นหนึ่งในผู้ก่อตั้ง BioMed และรองประธาน HKSGM แล้ว ยังเป็น Head of Division of Genomics and Bioinformatics, School of Biomedical Sciences, Chinese University of Hong Kong (CUHK) ซึ่งเป็นผู้เชี่ยวชาญระดับโลกสาขาชีวสารสนเทศศาสตร์ โรคทางพันธุกรรมของมนุษย์ และจุลชีววิทยาระดับโมเลกุล โดยเมื่อปี 2014 Prof. Tsui นำทีมจาก CUHK Medical School ถอดรหัสพันธุกรรมไรฝุ่นได้สำเร็จเป็นครั้งแรกของโลก ซึ่งถือเป็นความสำเร็จครั้งสำคัญต่อการวิจัยเกี่ยวกับสารก่อภูมิแพ้ และที่สำคัญ Prof. Tsui และทีมยังเป็นทีมแรก ๆ ในโลก ที่ประสบความสำเร็จในการถอดรหัสพันธุกรรมไวรัส SARS-CoV อีกด้วย ซึ่งความร่วมมือกับไบโอเทค จะนำองค์ความรู้ เทคโนโลยีและนวัตกรรม มาตอบโจทย์ความต้องการของประเทศ บนพื้นฐานการพัฒนาอย่างยั่งยืน เป็นอีกหนึ่งแนวทางที่ช่วยสร้างฐานความเข้มแข็งในด้านอุตสาหกรรมการพัฒนาจุลินทรีย์เสริมสุขภาพของไทย













